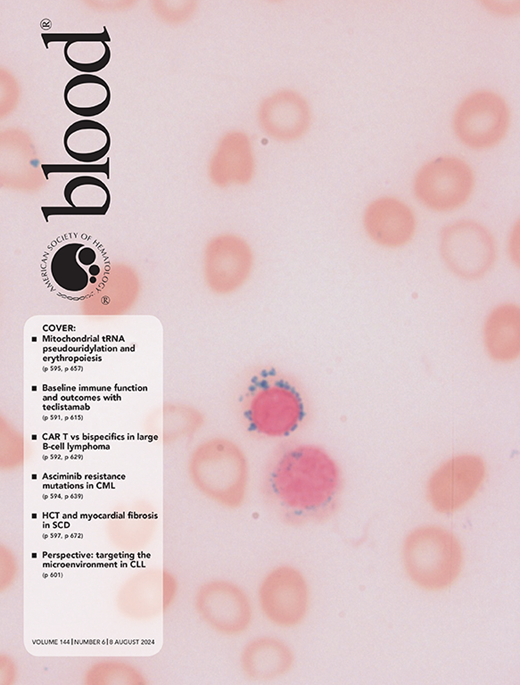

CAR T cells vs bispecific antibody as third- or later-line large B-cell lymphoma therapy: a meta-analysis
In this medfyle
A meta-analysis evaluated the efficacy and safety of CAR T-cell therapy compared to bispecific antibodies in treating R/R DLBCL. The findings demonstrated that CAR T-cell therapy significantly outperforms bispecific antibodies, achieving a higher complete response rate. This superiority in efficacy remains evident even after adjusting for factors like double-hit lymphoma. However, the study also highlighted increased incidences of severe adverse events like cytokine release syndrome and neurotoxicity associated with CAR T-cell therapy, underscoring the necessity for careful safety management.